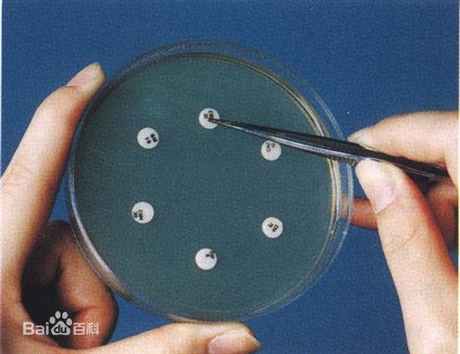
公司图片_北京普纳德科技有限公司 - 搜了网

北京宜德源

北京宜德源田野文化园图片
图片尺寸960x640
em>宜 /em> em>德源 /em>
图片尺寸1160x1160
"-宜德源田野文化园-北京景点/周边游-大众点评网
图片尺寸700x933
德州房产网>德州整租房>德城整租房>市区整租房>696_522
图片尺寸696x522
德州房产网>德州整租房>德城整租房>市区整租房>696_522
图片尺寸696x522
德州房产网>德州整租房>德城整租房>开发区整租房>696_522
图片尺寸696x522
公司图片_北京普纳德科技有限公司 - 搜了网
图片尺寸460x354
德州房产网>德州整租房>德城整租房>市区整租房>696_522
图片尺寸696x522
【11图】唐人电梯新房,精装一室一厅,房子干净,三八中路_德城市区整
图片尺寸696x522
德州房产网>德州整租房>德城整租房>市区整租房>696_522
图片尺寸696x522
【12图】城上城3室出租,3个空调,冰箱洗衣机都有,德兴北大道1199号_德
图片尺寸696x522
总经理_北京瑞康志德医药贸易有限公司招聘信息 - 北京58同城
图片尺寸1770x1180
作为一道传统中国菜,北京烤鸭甚至在当年成为了国宴插图
图片尺寸1000x600
德州房产网>德州整租房>德城整租房>市区整租房>696_522
图片尺寸696x522
气瓶柜(单瓶/双瓶/三瓶)_气瓶柜-北京德世科技有限公司
图片尺寸600x430
德州房产网>德州整租房>德城整租房>开发区整租房>696_522
图片尺寸696x522
【12图】罗庄新区 2室2厅1卫 94平 南北通透,德惠大道,近尚学路_德
图片尺寸696x522
北京全聚德烤鸭.
图片尺寸442x248
大兴经济开发区管委会指导下,上德中心所属集团公司北京格雷时尚科技
图片尺寸500x667
2022二胎从美中宜和到北京怡德
图片尺寸1080x1439